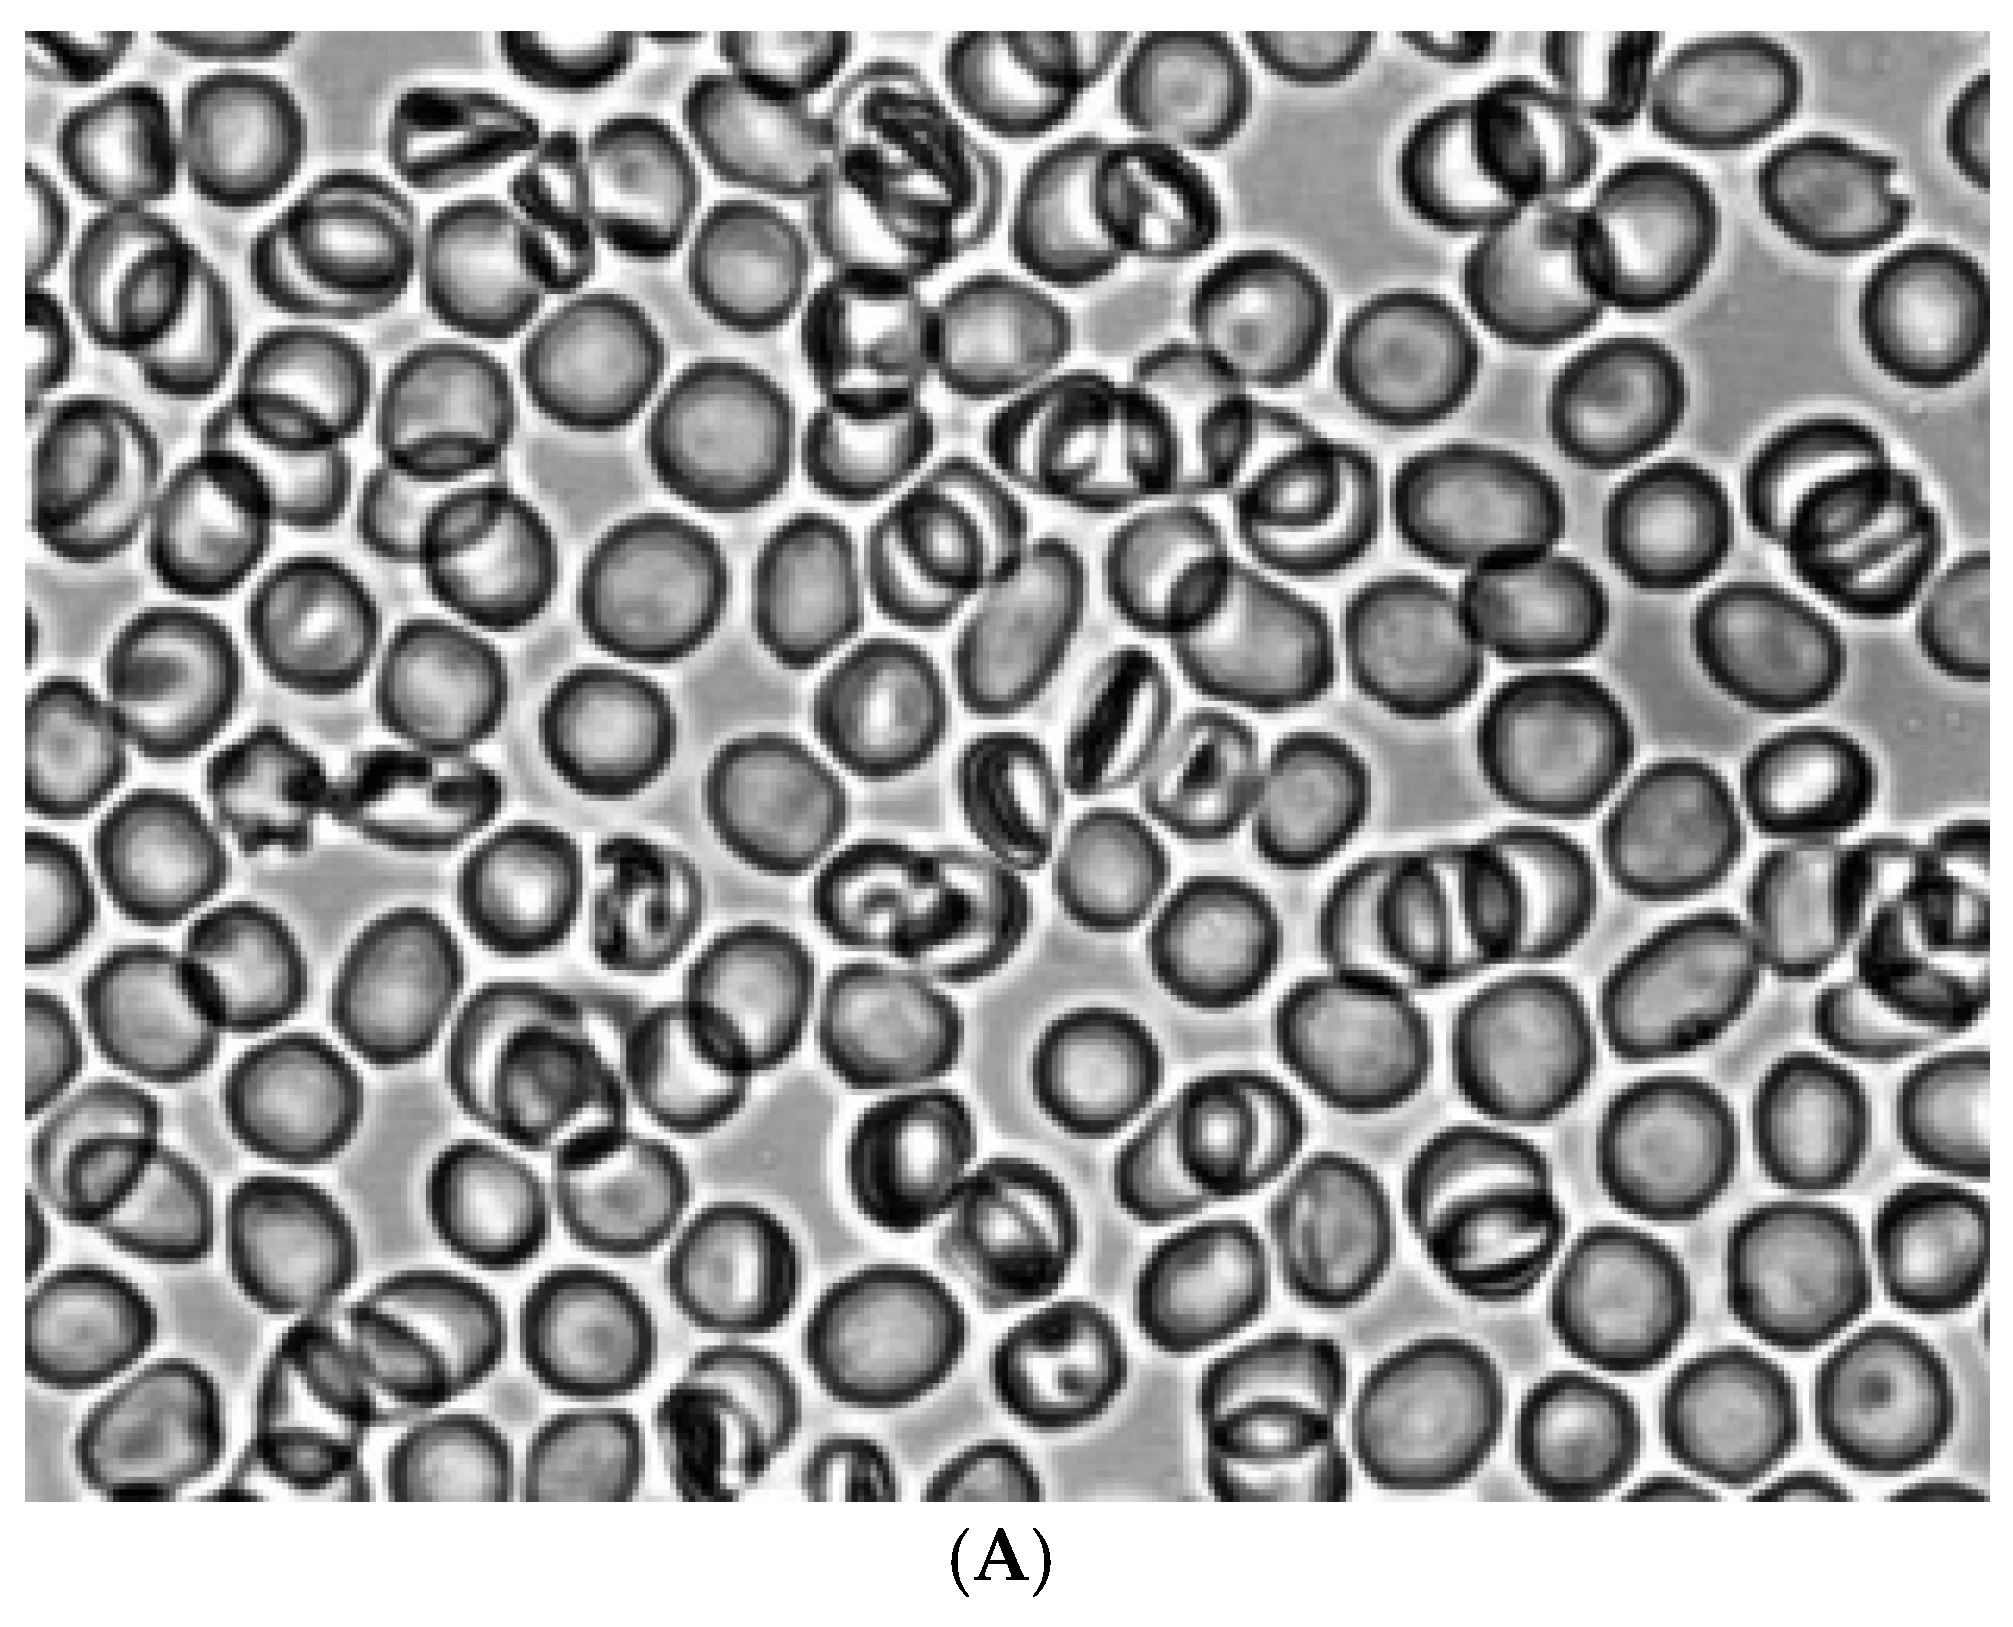
Preprints 173751 g006a
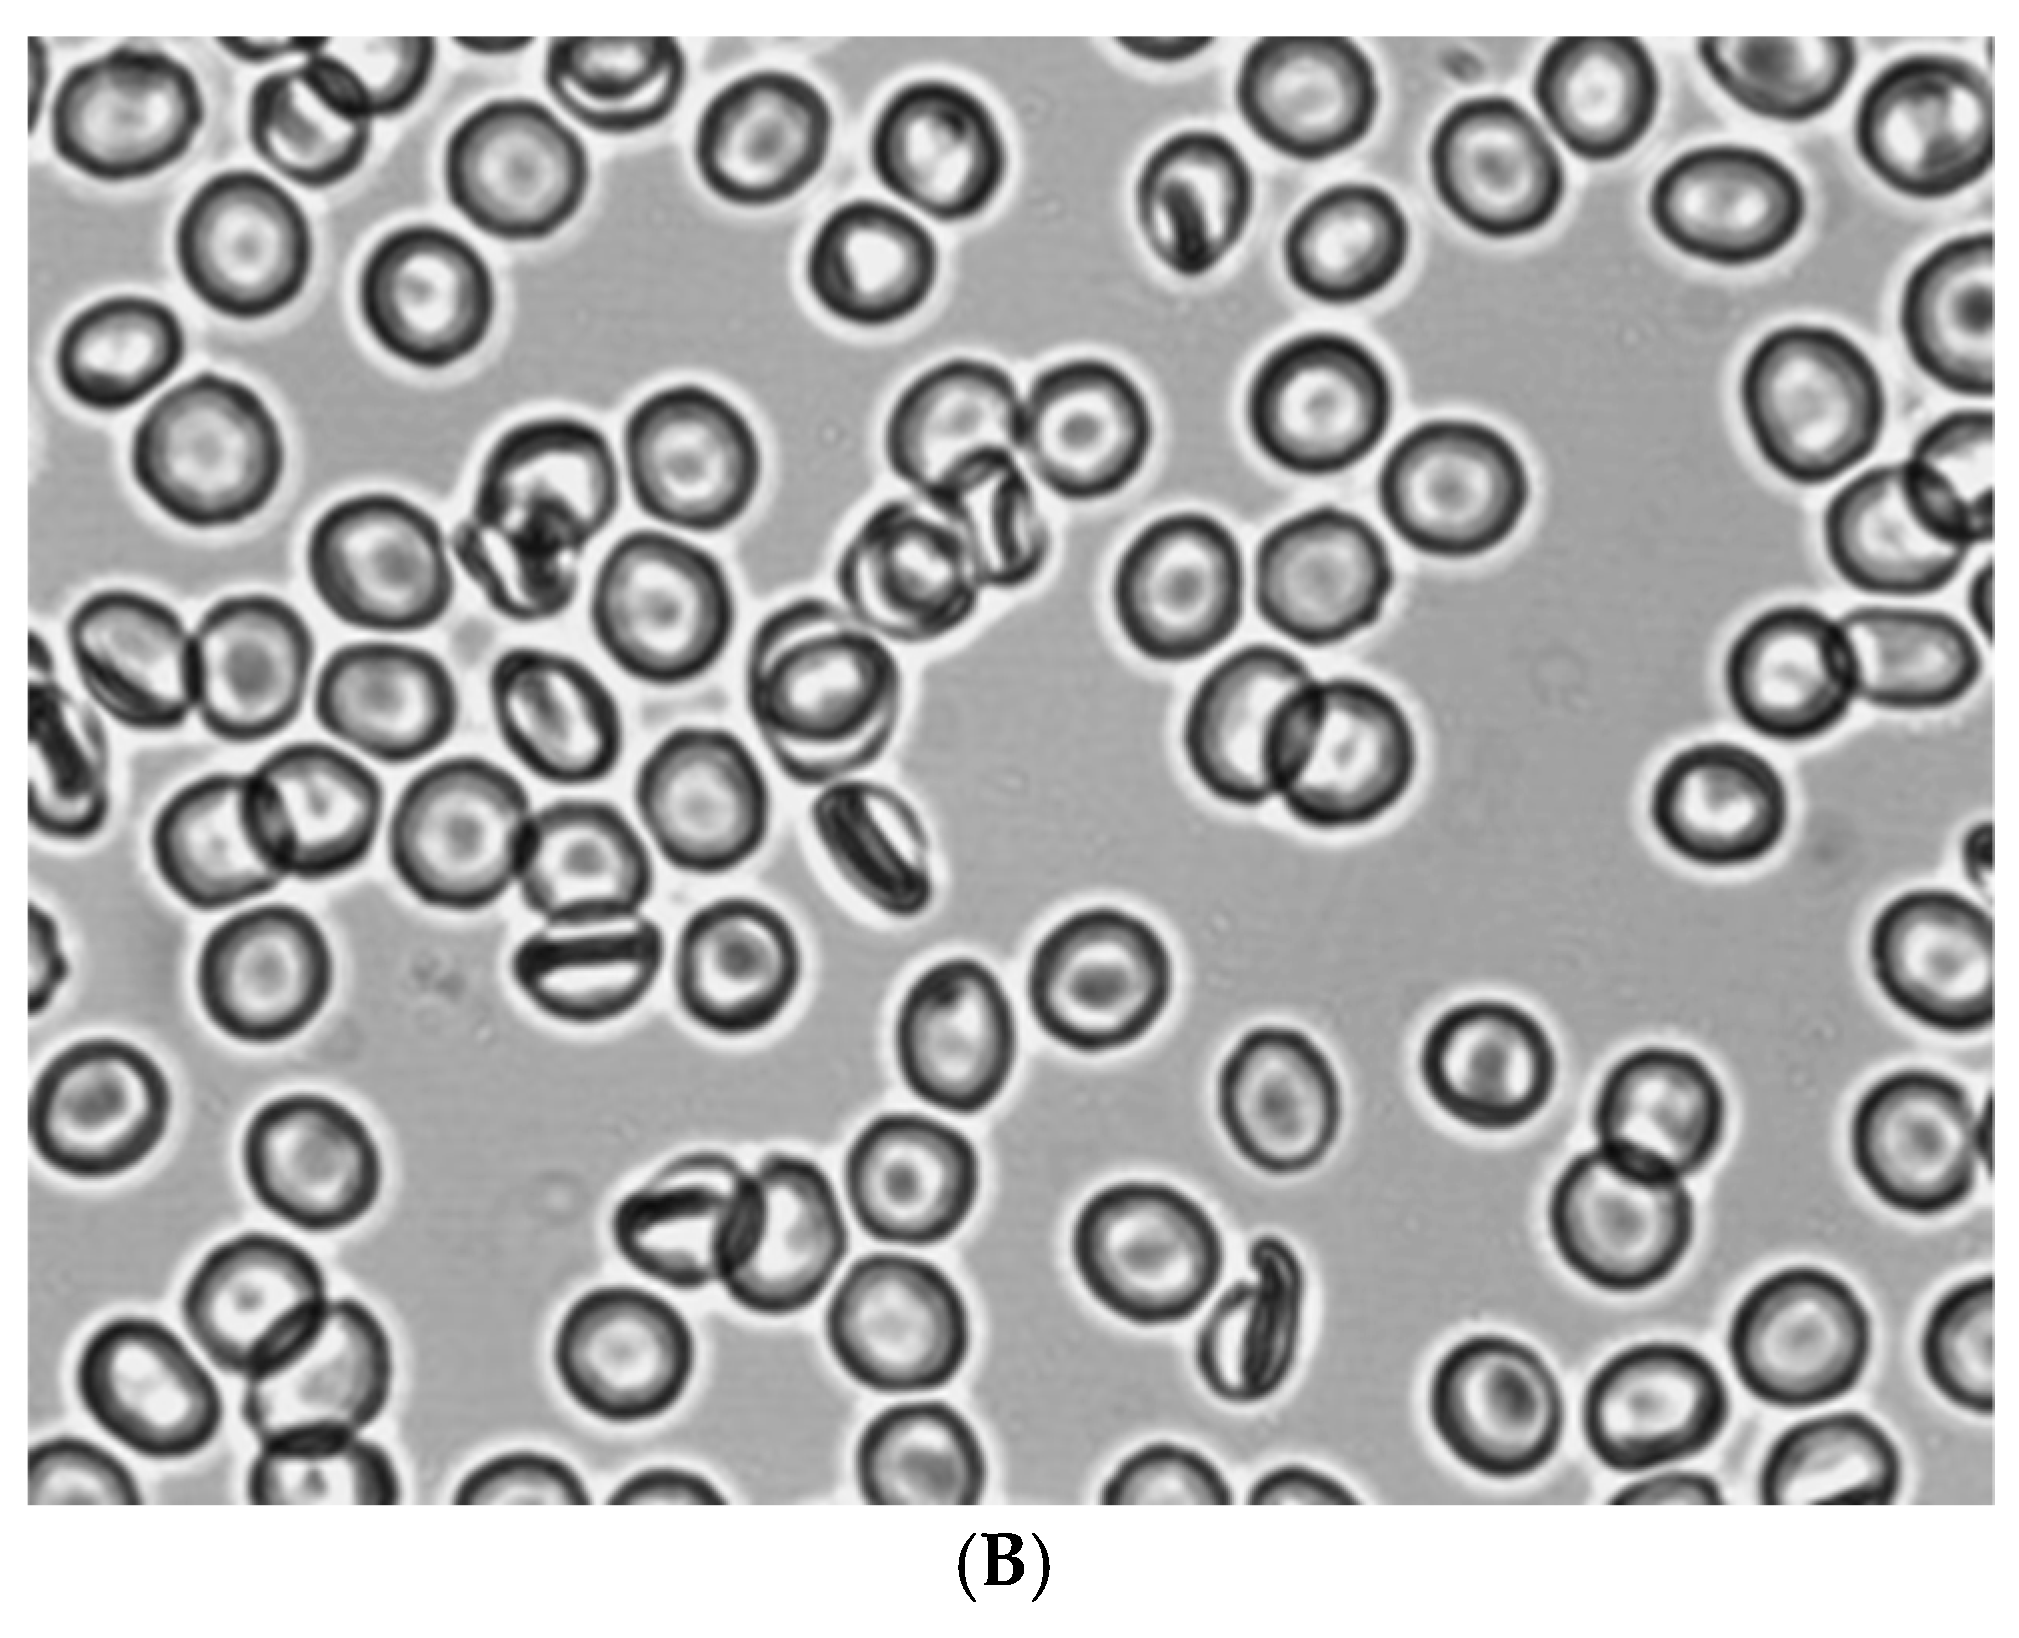
Preprints 173751 g006b
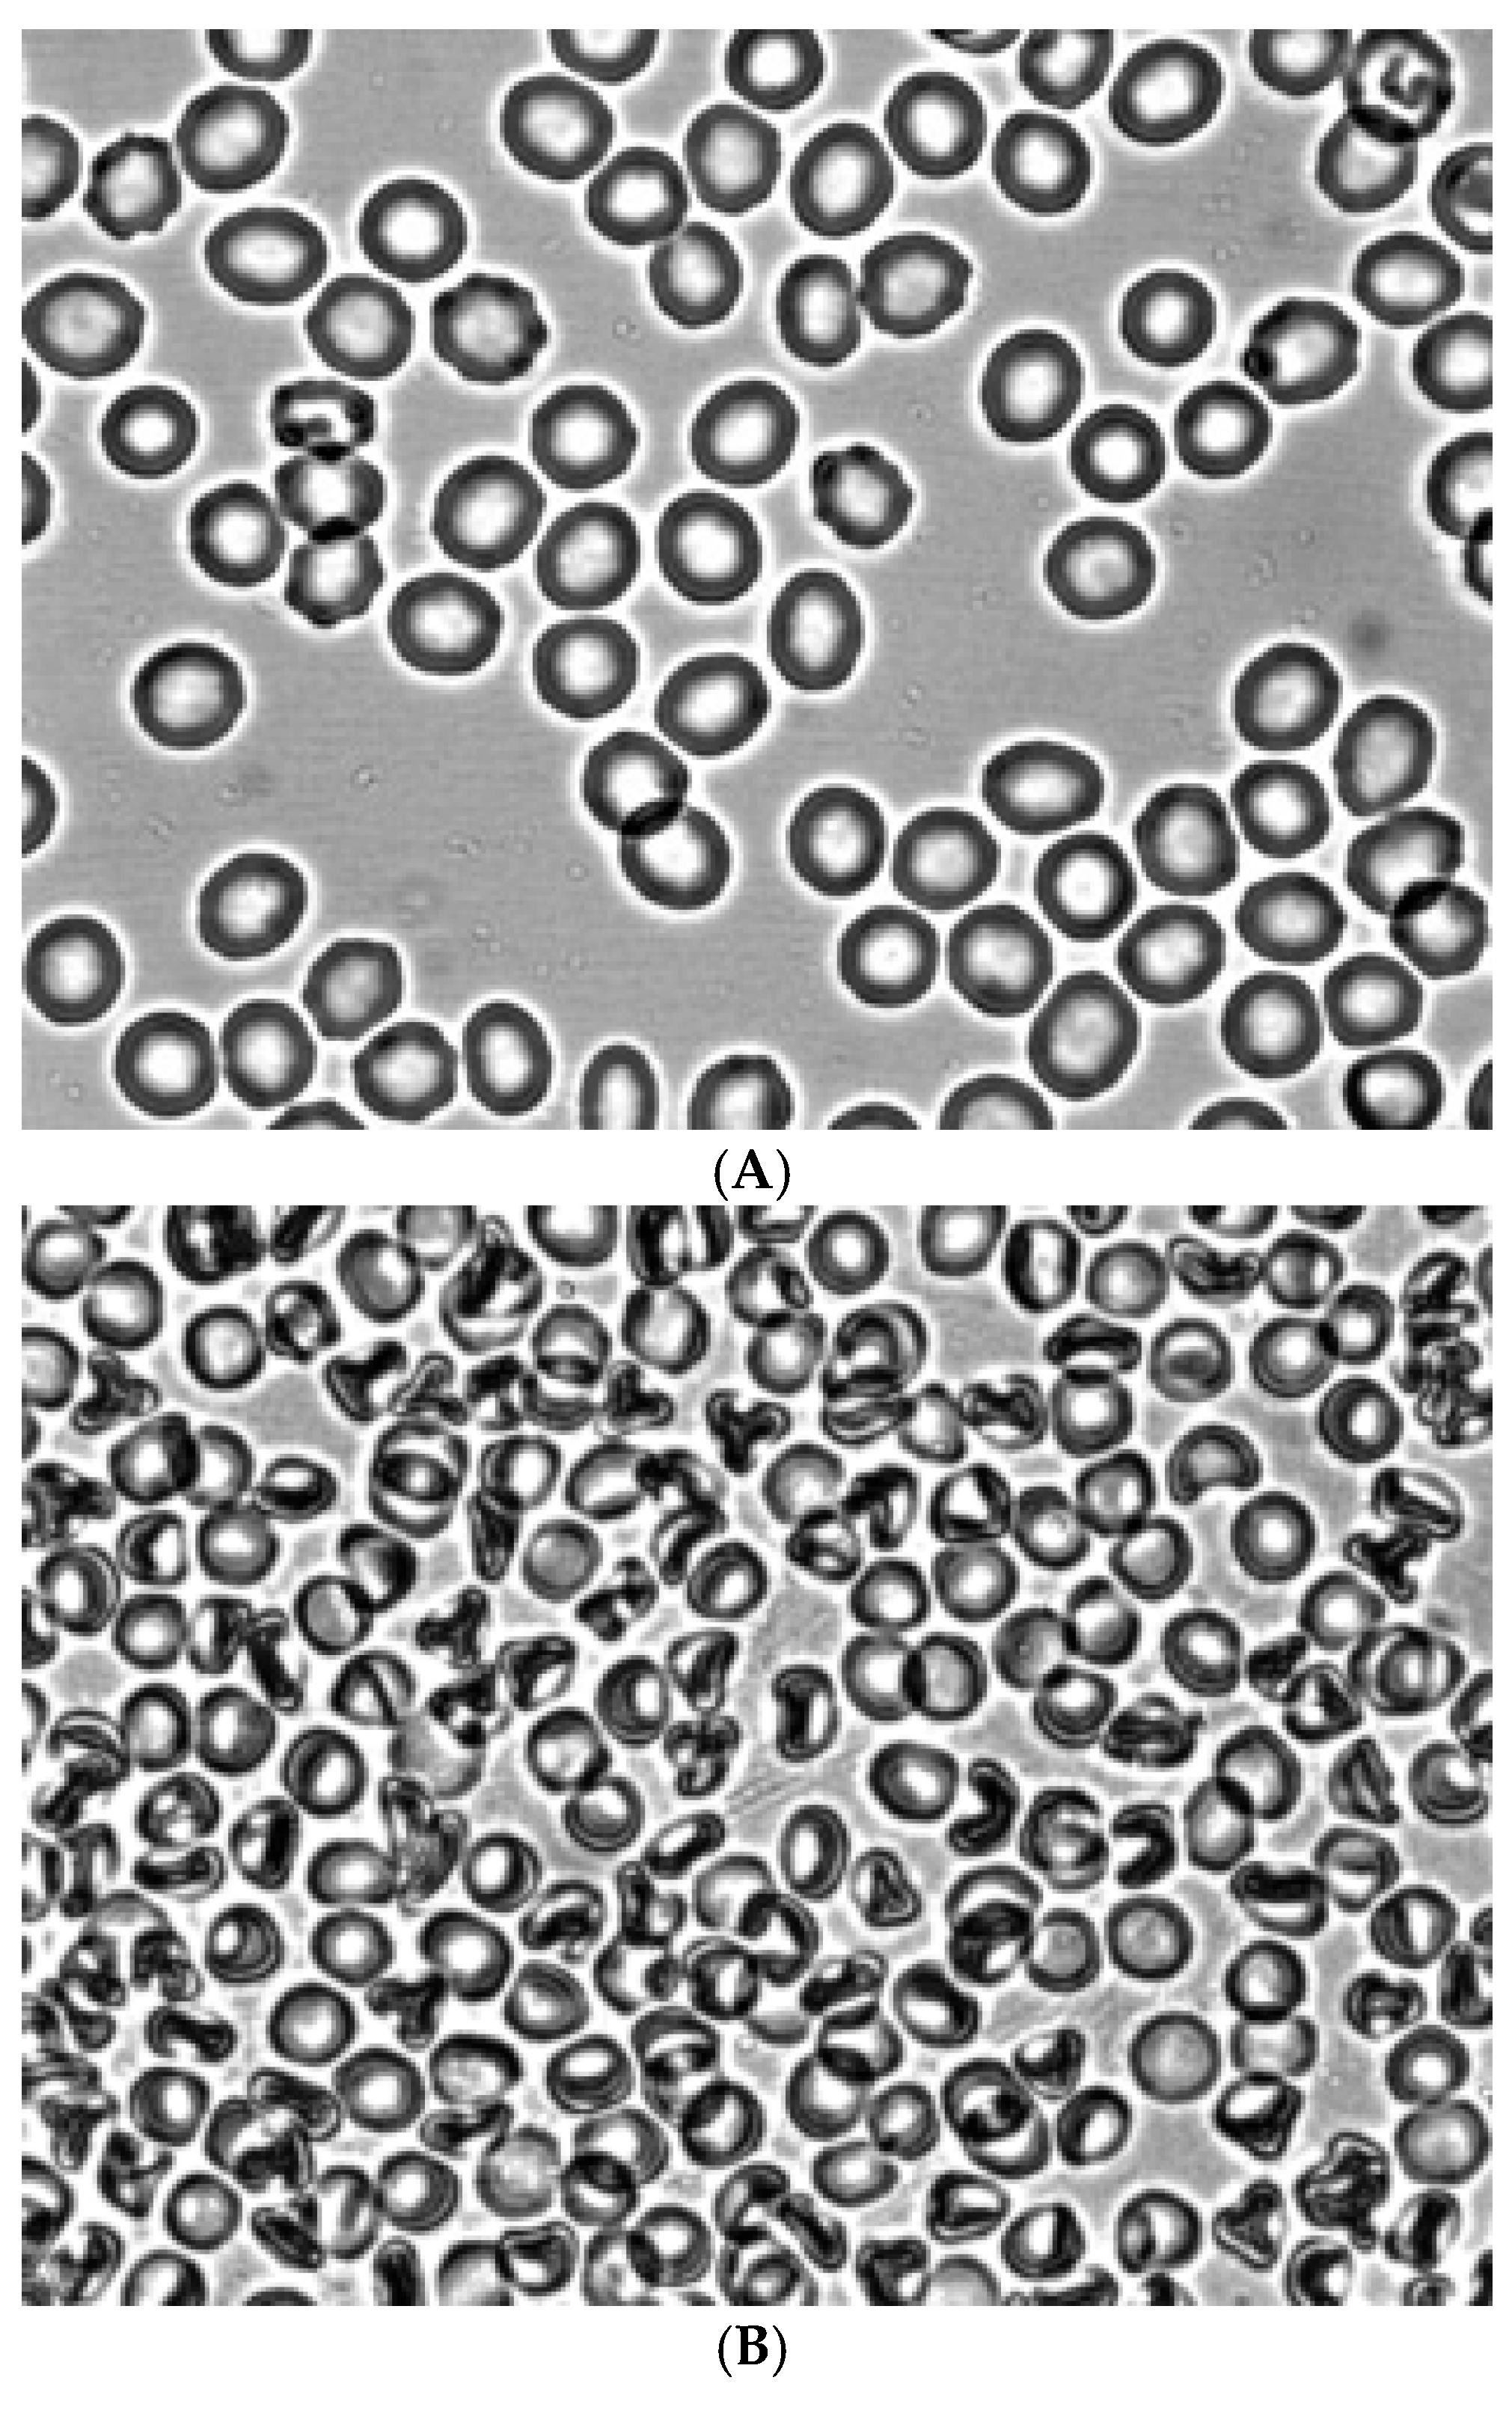
Preprints 173751 g002
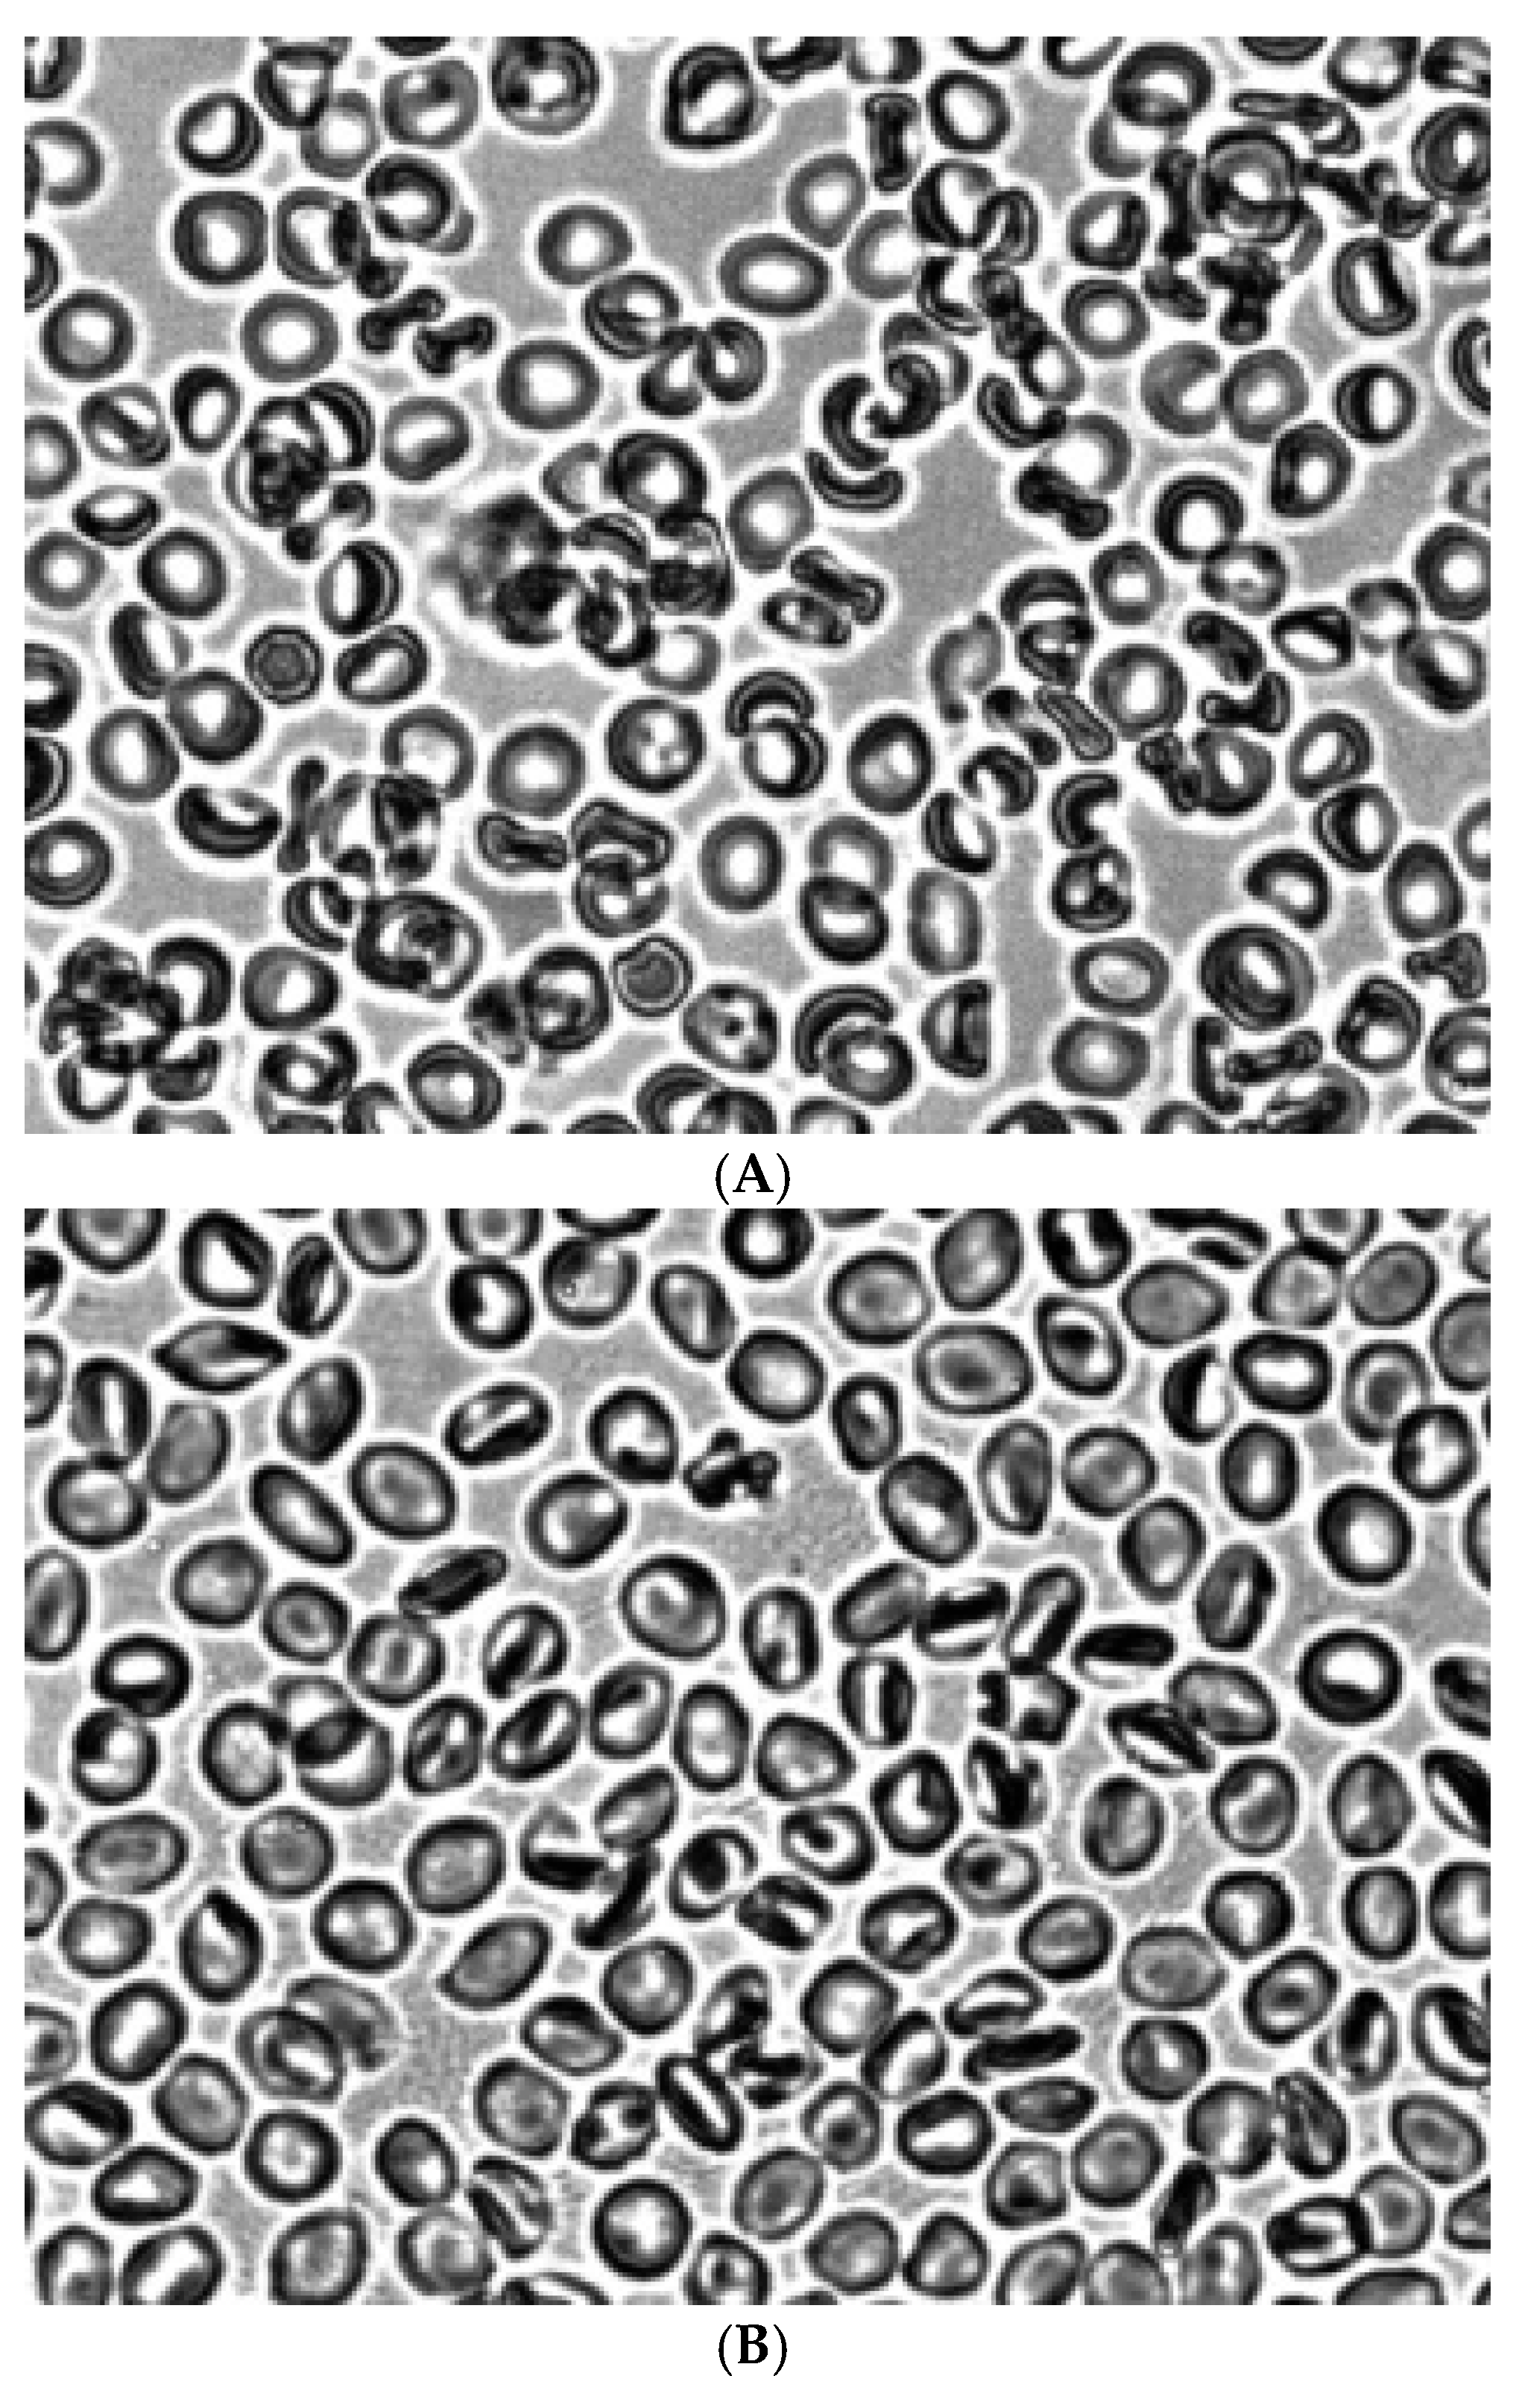
Preprints 173751 g003

Introduction
Red blood cell (RBC) aggregation is a reversible process of formation and destruction of RBC aggregates, which largely determines blood viscosity at low shear stress [
1,
2,
3]. As a consequence, the aggregation of RBCs significantly affects the efficiency of blood microcirculation and oxygen delivery to tissues. At the same time, the degree of RBC aggregation significantly changes in diabetes, hypertension, sepsis and many other diseases [
4,
5,
6]. This makes the study of RBCs aggregation an important task both for the development of blood rheology as a scientific direction and for clinical practice.
The process of erythrocyte aggregation is determined by two types of biophysical and physico-chemical factors - the properties of blood plasma and the properties of RBCs themselves, mainly the components of their membranes [
7].
Currently, two models of the mechanism of RBC aggregation have been proposed: bridge theory and depleted layer theory. According to the bridging model, the unification of cells into aggregates occurs when macromolecules form bridges between the membranes of neighboring cells [
8]. According to the depleted layer model, RBCs combine into aggregates due to the formation of a macromolecular (protein or polymer) depleted layer near the cell surface in comparison with the bulk phase. This leads to the appearance of an osmotic gradient that promotes cell convergence and interaction [
9]. However, none of these models is still generally accepted.
We hypothesized the mechanism of RBC aggregation based on a change in the spontaneous curvature of RBC membranes [
10,
11,
12]. According to this hypothesis, the formation of negative curvature of membranes at low shear stresses of RBCs leads to the appearance of stomatocytic forms of RBCs, followed by their aggregation into aggregates in autologous plasma and dextran 70. It is assumed that the formation of stomatocytes leads to the appearance binding sites on their membranes.
Previously, using a light microscope, it was shown that after mechanical mixing of a suspension of RBCs, a reversible transformation of discocytes into stomatocytes occurs [
13]. Later, the formation of stomatocytes was also observed in the shear flow at low shear stresses [
14,
15]. In this case, erythrocytes in the shear flow were fixed using glutaraldehyde. Recently, we have shown a lifetime change in the shape of erythrocytes before their aggregation in the form of rouleaux [
11]. Red blood cells transformed from discs into stomatocytes.
Acridine orange and Zn
2+ are known to induce reversible clustering of integral RBC membrane proteins [
16,
17,
18,
19]. In this case, RBCs treated with acridine orange [
19,
20] and Zn
2+[
20,
21] are transformed from discocytes into stomatocytes.
It seemed important to us to study the shape of RBCs in the shear flow at low shear stress and the agents leading to clustering of membrane proteins on the shape and aggregation of RBCs in autologous plasma and dextran 70 solution. The effect of shear stress, acridine orange, and Zn2+ on red blood cells is reversible. Therefore, after the action of shear stress, acridine orange and Zn2+ on erythrocytes, we fixed them in a solution of glutaraldehyde.
Previously, we assumed that erythrocytes of the stomatocytic form, after the influence of shear stress, have sites on the surface of their membranes for binding blood proteins and high-molecular dextran [
10,
11,
12]. To confirm this, we conducted model experiments with aggregation of pre-fixed glutaraldehyde discocytes and stomatocytes. To elucidate the mechanism of possible formation of discrete sites on the surface of stomatocyte membranes, the effect of acridine orange and Zn
2+ on the shape and aggregation of glutaraldehyde-fixed cells was studied.
Materials and Methods
Glutaraldehyde, acridine orange, ZnCI2 dextran 70 (MW= 70 kD),, (Sigma, USA) were used in the work. All other reagents were analytically pure.
The blood of 10 healthy volunteers was used in the work. Venous blood was collected in vacuum tubes containing 3.8% sodium citrate (9:1 ratio). The blood was centrifuged for 20 min at 2000 g. Platelets and leukocytes were removed. Then the RBCs were washed three times with an excess volume of saline solution. The washed RBCs were placed in buffered saline solution (10 mM Tris-HCI, 150 mM NaCI, pH 7.4) with 0.5% hematocrit. The shape of RBCs at low shear stress in the shear flow was studied in a specially designed device (
Figure 1) [
12,
22]. For this purpose, a suspension of washed RBCs in buffered saline solution (10 mM tris - HC, 150 mM NaCI pH, 7.4) was injected through an opening in the inner cylinder into the gap between the cylinders and a shear stress of 3 Pa was created. After 20 seconds, a glutaraldehyde solution was injected through the hole to a final concentration of 0.25% and the motor rotation was stopped. The fixed erythrocytes were washed twice in buffered saline solution.
RBCs were incubated with acridine orange (0.2 mM) and Zn
2+ (1 mM) prepared in buffered saline solution at room temperature for 30 minutes. After that, RBCs were fixed in 0.25% glutaraldehyde solution for 60 min. Next, the RBCs were washed twice in buffered saline solution. To study the aggregation of control cells and stomatocytes fixed with glutaraldehyde, they were placed in autologous plasma or a 3% dextran 70 solution (hematocrit 5%). A drop of the resulting mixture of autologous plasma and dextran 70 solution with RBCs was placed on a slide, mixed, and studied at a total magnification of 1000x [
6,
10]. We used a light microscope (Primo Star Carl Zeiss, Germany) equipped with a megapixel digital color television camera.
Results
Figure 2 shows the morphology of RBCs before (
Figure 2A) and during the creation of shear stress in the shear flow (
Figure 2B). It can be seen that under shear stress, the bulk of the discocytes turn into stomatocytes. Stomatocytes fixed in a glutaraldehyde solution were aggregated after being placed in autologous plasma (
Figure 4A) and a 3% dextran 70 solution (
Figure 5A).
Figure 3 shows the morphology of RBCs after treatment with acridine orange. It can be seen that treatment of intact erythrocytes with acridine orange leads to the formation of stomatocytes (
Figure 3A). Treatment of Zn
2+ RBCs also stimulated the formation of stomatocytes (
Figure 3B).
Microscopic analysis showed that stomatocytes obtained after treatment with acridine orange and fixed with glutaraldehyde form pronounced aggregates in autologous plasma (
Figure 4B) and dextran 70 solution (
Figure 5B). It should be noted that after treatment of erythrocytes with glutaraldehyde, the cell membranes lose their elasticity. This is probably due to the fact that stomatocytes can not form an aggregation in the form of rouleaux. Intact discoidal RBCs fixed in glutaraldehyde solution did not aggregate in autologous plasma (
Figure 6A) and dextran 70 solution (
Figure 6B).
Figure 4.
Aggregation in autologous plasma of glutaraldehyde-fixed stomatocytes obtained in shear flow under shear stress 3 Pa (A), treated with acridine orange (B) and Zn2+(C). Magnification 1000x.
Figure 4.
Aggregation in autologous plasma of glutaraldehyde-fixed stomatocytes obtained in shear flow under shear stress 3 Pa (A), treated with acridine orange (B) and Zn2+(C). Magnification 1000x.
Figure 5.
Aggregation of glutaraldehyde-fixed stomatocytes in a 3% dextran 70 solution obtained in a shear flow under shear stress 3 Pa (A), treated with acridine orange (B) and Zn2+(C). Magnification 1000x.
Figure 5.
Aggregation of glutaraldehyde-fixed stomatocytes in a 3% dextran 70 solution obtained in a shear flow under shear stress 3 Pa (A), treated with acridine orange (B) and Zn2+(C). Magnification 1000x.
Figure 6.
Control RBCs fixed with glutaraldehyde in autologous plasma (A) and a solution of 3% dextran 70 (B). Magnification 1000x.
Figure 6.
Control RBCs fixed with glutaraldehyde in autologous plasma (A) and a solution of 3% dextran 70 (B). Magnification 1000x.
Discussion
In this work, we have shown that at low shear stress, the shape of RBCs changes in the shear flow: discocytes transform into stomatocytes. This is consistent with previously published reports [
14,
15]. Glutaraldehyde-fixed stomatocytes were aggregated in autologous plasma and dextran 70 solution. At the same time, fixed discoidal RBCs did not aggregate in autologous plasma and dextran 70 solution. Our data are consistent with the previously obtained data that the aggregation of glutaraldehyde-fixed normal RBCs is practically absent [
7].
It is known that stomatocytes, unlike echinocytes, bind immunoglobulins 3-8 times more than normal cells [
23]. Earlier, we showed that RBCs having an echinocytic form did not aggregate in autologous plasma [
24].
It is known that acridine orange and Zn
2+ induce not only the aggregation of integral RBC membrane proteins, but also the exposure of negatively charged phosphatidylserine to the outer half of the bilayer [
25]. However, the involvement of phosphatidylserine in the mechanism of erythrocyte aggregation is unlikely. This is evidenced by the data that echinocytes with a high content of phosphatidylserine on the outer half of the membranes do not aggregate in autologous plasma and dextran 70 solution [
11,
24].
Based on the data we have obtained, it can be argued that the formation of stomatocytes leads to the appearance of discrete binding sites on their membranes. The formation of discrete regions is apparently related to the reversible clustering of integral proteins.
Thus, at low shear stress, stomatocytic cells are formed in the shear flow. As a result, discrete regions appear on the membranes for binding protein molecules and dextran 70, which are absent in discoidal RBCs. The formation of bridges from protein molecules and dextran 70 between the membranes of neighboring cells leads to their aggregation.
Funding
The study did not receive any special grants from funding organizations in the government, commercial or non-profit sectors.
Institutional Review Board Statement
Ten healthy blood donors gave written informed consent. The study protocol was approved by the Local Ethics Committee for Human Research at the Privolzhsky Research Medical University (Russia) (number of investigation 45) from 7/07/2025.
Conflicts of Interest
The authors state that they are unaware of any competing financial interests or personal connections that could influence the work described in this article. Statement of Ethical standards Ten healthy blood donors gave written informed consent. The study protocol was approved by the Local Ethics Committee for Human Research at the Privolzsky Research Medical University (Russia) (number of studies 45).
References
- Barshtein, G., R. Ben-Ami, R., and Yedgar, S. (2007) Role of red blood cell flow behavior in hemodynamics and hemostasis, Expert Rev. Cardiovasc. Ther. 5, 743–752. [CrossRef]
- Baskurt, O.K., and Meiselman, H.J. (2013) Erythrocyte aggregation: basic aspects and clinical importance, Clin. Hemorheol. Microcirc., 53, 23-37. [CrossRef]
- Rampling, M, Meiselman H.J, Neu, B, and Baskurt, O.K. (2014) Influence of cell-specific factors on red blood cell aggregation, Biorheology , 41, 91-112. [CrossRef]
- Le Devehat,C., Vimeux, M., Bondoux, G., and Bertrand A. (1989) Red blood cell aggregation and disaggregation in diabetes mellitus, Clin.Hemorheol.Microcirc. 9, 845-854. [CrossRef]
- Ami, R.B., Barshtein, G., Zeltser, D., Goldber Y., Shapira, I., Roth, A., Keren, G., Miller, H., Prochorov, V., Eldor, A., Berlinger, S., and Yedgar, S.(2001) Parameters of red blood cell aggregation as correlates of the inflammatory state, Amer. J. Physiol. Heart Circ.Physiol., 280, H1982-1988. [CrossRef]
- Sheremet'ev, Yu.A., Popovicheva, A.N., M.M. Rogozin, M.M., and Levin, G.Ya. (2019) Red blood cell aggregation, disaggregation and aggregate morphology in autologous plasma and serum in diabetic foot disease, Clin. Hemorheol. Microcirc., 72 (2019) 221-227. [CrossRef]
- Baskurt, O.K., and Meiselman, H.J. (1997) Cellular determinants of low-shear blood viscosity, Biorheology, 34, 235-247,.
- Chien, S., and Jan, K.M. (1973) Red cell aggregation by macromolecules: role of surface adsorption and electrostatic repulsion, J. Supramol. Struct., 1, 385 -409. [CrossRef]
- Neu, B., and Meiselman, H.J. (2002) Depletion-mediated red blood cell aggregation in polymer solutions, Biophys. J., 83, 2482-2490. [CrossRef]
- Sheremet’ev, Yu.A., Popovicheva, A.N., and Levin, G.Ya. (2014) Lysophosphatidic acid and human erythrocyte aggregation, Cell and Tissue Biology, 8, 237-243. [CrossRef]
- Sheremet'ev, Yu. (2025) Study of the role of erythrocytes shape in mechanism of their aggregation, Preprints. [CrossRef]
- Sheremet'ev, Yu.A. (2025) Influence of metabolic depletion of red blood cells on their rheological properties, Preprints. [CrossRef]
- Jay, A.W.L. (1975) Geometry of the human erythrocyte. 1. Effect of albumin on cell geometry, Biophys. J., 15, 205-222. [CrossRef]
- Lanotte, L., Mauer, J., Mendez, S., Fedosov, D.A., Fromantal, J.M., Nicoud F., Compper, G., and Abkarian., M. (2016) Red cell dynamics morphological govern blood shear thinning under microcirculary flow condition, Proc. Natl. Acad. Sci. USA, 113, 13289-13294.
- Mauer, J., Mendez, S., Lannote L., Nicoud, F., Abkarian, M., Compper, G., and Fedosov, D.A. (2018) Flow - induced transitions of red blood cell shapes under shear, Phys.Rev. Lett., 121, 118103. [CrossRef]
- Turrini, F., Arese, P., Yuan, J., and Low, P.S. (1991) Clustering of integral membrane proteins of human erythrocyte membrane stimilates autologous IgG binding, complement deposition and phagocytosis, J. Biol. Chem., 266, 23611 -23617. [CrossRef]
- Turrini, F. Mannu, F., Arese, P., Yuan, J., and Low, P.S. (1993) Characterization of the autologous antibodies that opsonize erythrocytes with clustered integral membrane proteins, Blood, 81, 3146-3252.
- Lelkes, G., Lelkes, G., Mersi, K.S., and Hollan, S.R. (1983) Intense, reversible aggregation of intramembrane particles in non- haemolized human erythrocytes, Biochim. Biophys. Acta, 732, 48-57.
- Lelkes, G., Fodor, I., Lelkes, G., and Hollan, S.R. (1986) The mobility of intramembrane particles in non-haemolysed human erythrocytes. Factors affecting acridine-orange-induced particle aggregation, J. Cell Sci., 86, 1, 57 -67.
- Sheremet'ev, Yu.A., Popovicheva, A.N., Uspensky, A.N., Alexandrov, A.A., and Uspenskaya, O.A. (2017) A method for lifetime assessment of the effect of reagents on the formation of stomatocytes, RU Patent 2629609, publ. 30.08.2017, Byul. No. 25.
- Sergunova, V., Leesment, S., Koslov, A., Inozemtsev, V., Platitsina, P., Lyapunova, S., Onufrievich, A., Polyanov, V., and Sherstyukova, E. (2022) Investigation of red blood cells by atomic force microscopy, Sensors, 22,1-13. [CrossRef]
- Sheremet'ev, Yu.A., Popovicheva, A.N., and Levin, G.Ya. (2018) A study of the mechanism of the FeCI3 - induced aggregation of human erythrocytes, Biophysics, 63, 716-721. [CrossRef]
- Cosgrove, P., and Sheetz, M.P. (1982) Effect of cell shape on extravascular hemolysis, Blood, 59, 421-427.
- Sheremet’ev, Yu.A., Popovicheva, A.N., Egorihina, M.N., and Levin, G.Ya. (2013) Study of the relationship between shape and aggregation change in human erythrocytes, Biophysics, 58, 193-196. [CrossRef]
- Koshkaryev, A., Livshits, L., Pajic-Lijakovic, I., Gural, A., Barshtein, G., and Yedgar, S. (2020) Non- oxidative band - 3 clustering agents cause the externalization of phosphatidylserine on erythrocytes surfaces by a calcium- independent mechanism, Biochim. Biophys. Acta,1862, 183231. [CrossRef]
|
Disclaimer/Publisher’s Note: The statements, opinions and data contained in all publications are solely those of the individual author(s) and contributor(s) and not of MDPI and/or the editor(s). MDPI and/or the editor(s) disclaim responsibility for any injury to people or property resulting from any ideas, methods, instructions or products referred to in the content. |
© 2025 by the authors. Licensee MDPI, Basel, Switzerland. This article is an open access article distributed under the terms and conditions of the Creative Commons Attribution (CC BY) license (http://creativecommons.org/licenses/by/4.0/).